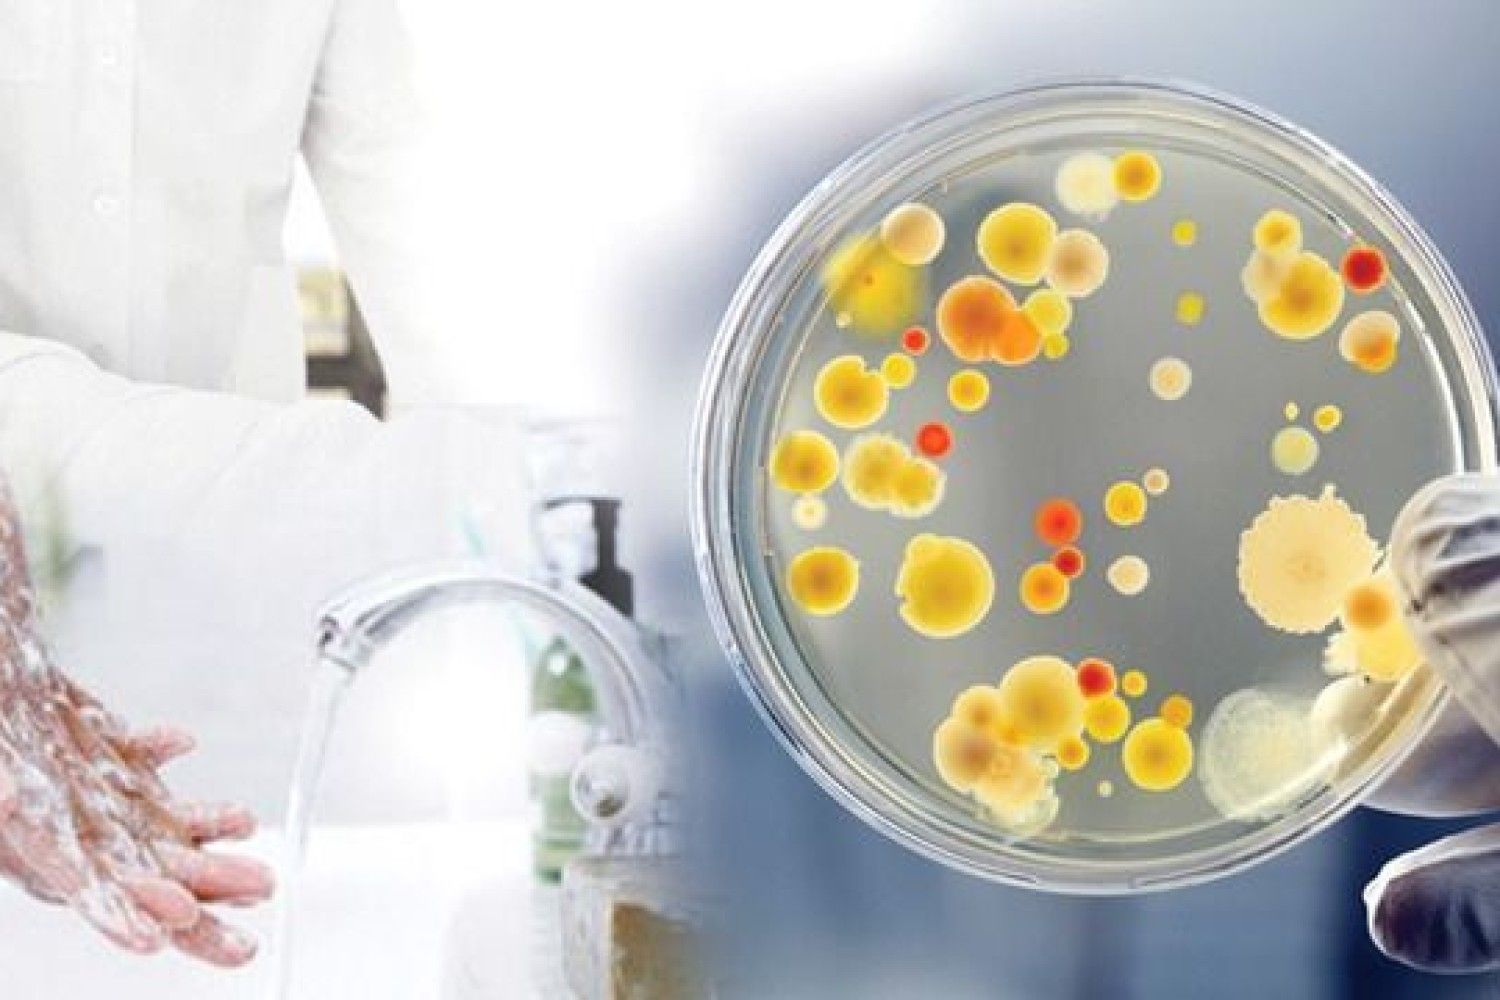

Выявление сальмонеллеза
Выявление сальмонеллеза 106 фото
Гоблин mexxanik книги
Pagespeed web dev
Душевая стойка frattini
Веселый роджер отзывы
Крымский мост парк горького
Хлеб в духовке готовится
Как использовать свекольный отвар после варки свеклы
Hotpoint ariston ltf
Аэропорт набережных челнов сайт
Переделка песен начальнику
Сайт газеты ветеран
Еврошина ульяновск московское
Сайт тосненского техникума
Курение запрещено статья
Погода в абатске тюменской на день
Значения карт казанова
Вологда отопительный
L eau kenzo hyper wave pour homme
Shop tycoon игры
Хлоргексидин в ампулах